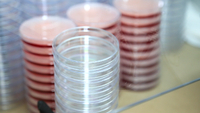

-

UFG INST UFG HC CENAS 24
-

UFG INST UFG HC CENAS 14
-

UFG INST UFG HC CENAS 08
-

UFG INST UFG HC CENAS 07
-

UFG INST UFG CONPEEX CENAS 28
-

UFG INST UFG CONPEEX CENAS 27
-

UFG INST UFG CONPEEX CENAS 19
-

UFG INST UFG CONPEEX CENAS 05
-

UFG INST UFG CEROF CENAS 24
-

UFG INST UFG CEROF CENAS 21
-

UFG INST UFG CEROF CENAS 03
-

UFG INST UFG BIBLIOTECA COLEMAR CENAS 04
-

UFG 20241204 INST UFG NDH CENAS 04
-

UFG 20241129 INST UFG PLANETARIO CENAS 05 1
-

UFG 20241128 INST UFG LIFOTON
-

UFG 20241121 INST UFG PRACA UNIVERSITARIA DRONE 02
-

UFG 20241121 INST UFG POLO SUSTENTAVEL DRONE 04
-

UFG 20241121 INST UFG PARQUE TECNOLOGICO DRONE 01
-

UFG 20241121 INST UFG LIFE DRONE FACHADA 03
-

UFG 20241121 INST UFG HC DRONE FACHADA 05
-

UFG 20241121 INST UFG HC DRONE FACHADA 04
-

UFG 20241121 INST UFG FEFD DRONE 06 -004
-

UFG 20241121 INST UFG FCT DRONE FACHADA 04
-

UFG 20241121 INST UFG FACHADA REITORIA DRONE FACHADA 03
-

UFG 20241121 INST UFG ENERGIA SOLAR DRONE 06
-

UFG 20241121 INST UFG CRTI DRONE FACHADA 01
-

UFG 20241121 INST UFG CMBIOTECS DRONE FACHADA 01
-

UFG 20241121 INST UFG CENTRO CULTURAL DRONE FACHADA 01
-

UFG 20241121 INST UFG CENTRO CULTURAL DRONE 04
-

UFG 20241121 INST UFG AVENIDAS SAMAMBAIA DRONE 03
-

UFG 20241118 INST UFG ENG ALIMENTO CENAS 04
-

UFG 20241118 INST UFG CEMPA CERRADO CENAS 09
-

UFG 20241118 INST UFG CEMPA CERRADO CENAS 08
-

UFG 20241118 INST UFG CEMPA CERRADO CENAS 03
-

UFG 20241114 INST UFG GEOLOGIA CENAS 21
-

UFG 20241114 INST UFG GEOLOGIA CENAS 17
-

UFG 20241114 INST UFG GEOLOGIA CENAS 08
-

UFG 20241114 INST UFG ESTUDANTES PCD CENAS 05
-

UFG 20241114 INST UFG ESTUDANTES PCD CENAS 03
-

UFG 20241114 INST UFG ENG CONSTRUCAO CENAS 02
-

UFG 20241113 INST UFG EA MELHORAMENTO GENETICO CENAS 18
-

UFG 20241113 INST UFG EA MELHORAMENTO GENETICO CENAS 08
-

UFG 20241112 INST UFG HORTA CENAS 14
-

UFG 20241112 INST UFG HORTA CENAS 08
-

UFG 20241112 INST UFG CPA CENAS 33
-

UFG 20241112 INST UFG CPA CENAS 26
-

UFG 20241112 INST UFG CPA CENAS 19
-

UFG 20241112 INST UFG CPA CENAS 13
-
UFG 20241112 INST UFG CPA CENAS 03
-

UFG 20241112 INST UFG CENTRO CULTURAL CENAS 40
-

UFG 20241112 INST UFG CENTRO CULTURAL CENAS 19
-

UFG 20241112 INST UFG CALOURO 08
-

UFG 20241112 INST UFG CALOURO 07
-

UFG 20241112 INST UFG ATENDIMENTO ODONTO CENAS 02
-

UFG 20241112 INST UFG ATENDIMENTO ODONTO CENAS 02 1
-

UFG 20241111 INST UFG CMBIOTECS CENAS 09
-

UFG 20241111 INST UFG CMBIOTECS CENAS 08
-

UFG 20241111 INST UFG CMBIOTECS CENAS 01
-

UFG 20241108 INST UFG CIDADE GOIAS CENAS 033 1
-

UFG 20241108 INST UFG CIDADE GOIAS CENAS 028 1
-

UFG 20241108 INST UFG CIDADE GOIAS CENAS 022 1
-

UFG 20241105 INST UFG PISCINA CENAS 11
-

UFG 20241105 INST UFG ESTUDANTE QUESTIONADO CENAS 04
-

UFG 20241105 INST UFG ESTUDANTE QUESTIONADO CENAS 01
-

UFG 20241105 INST UFG CASA ESTUDANTE 03
-

UFG 20241105 INST UFG CASA ESTUDANTE 02
-

UFG 20241101 INST UFG CRTI CENAS 27
-

UFG 20241101 INST UFG CRTI CENAS 13
-

UFG 20241101 INST UFG CRTI CENAS 07
-

UFG 20241101 INST UFG BREAKING CENAS 01
-

UFG 20241028 INST UFG BATERIA CENAS 13
-

UFG 20241028 INST UFG BATERIA CENAS 11
-

UFG 20241028 INST UFG BATERIA CENAS 10
-

UFG 20241025 INST UFG FORMATURA CENAS 16
-

UFG 20241023 INST UFG FACULDADE FARMACIA CENAS 62
-

UFG 20241023 INST UFG FACULDADE DIREITO CENAS 02
-

UFG 20241022 INST UFG AULA LIBRAS CENAS 07
-

UFG 20241022 INST UFG AULA LIBRAS CENAS 05
-

UFG 20241022 INST UFG AULA LAB CENAS 06
-

UFG 20241022 INST UFG AULA LAB CENAS 04
-

UFG 20241022 INST UFG AULA LAB CENAS 01
-

UFG 20241021 INST UFG FACHADA REITORIA CENAS 08 1
-

UFG 20241021 INST UFG FACHADA REITORIA CENAS 06 1
-

UFG 20241021 INST UFG CEIA CENAS 18
-

UFG 20241021 INST UFG CEIA CENAS 17
-

UFG 20241021 INST UFG CEIA CENAS 10
-

UFG 20241021 INST UFG CEIA CENAS 05
-

UFG 20241018 INST UFG USINA CENAS 02
-

UFG 20241017 INST UFG GALERIA FAV CENAS 06
-

UFG 20241009 INST UFG DATA UFG CENAS 09
-

INST UFG DATA UFG CENAS 07
-

INST UFG DATA UFG CENAS 03
-

Data UFG - Cena 03
-

Data UFG - Cena 02
-

Data UFG - Cena 01